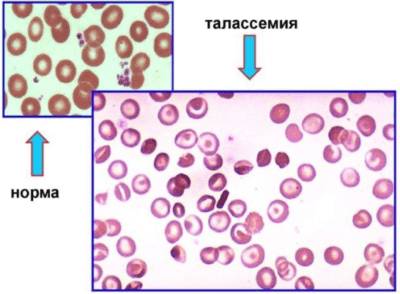

Содержание
Что это за болезнь? Патология характеризуется нарушением цепей гемоглобина в эритроцитах. В результате вместо нормальных компонентов крови появляется множество клеток, имеющих вид мишени. При этой болезни нарушается перенос кислорода к тканям и возникает кислородное голодание, которое ведёт к развитию симптомов болезни.
Что это такое?
Это группа заболеваний, которые передаются по наследству. Её характерный признак: кислородное голодание, возникающее из-за нарушения производства здоровых эритроцитов, а они, в свою очередь, ухудшают транспортировку кислорода к тканям.
Вследствие, это приводит к анемии, которая длится всю жизнь.
Врачи подчеркивают важность осведомленности о талассемии, наследственном заболевании, влияющем на производство гемоглобина. Это состояние может привести к анемии, усталости и другим серьезным осложнениям. Специалисты отмечают, что ранняя диагностика и регулярное наблюдение позволяют значительно улучшить качество жизни пациентов. Генетическое консультирование играет ключевую роль, особенно для семей с историей заболевания. Врачи рекомендуют проводить скрининг на талассемию в регионах с высокой распространенностью, чтобы выявить носителей и предотвратить передачу болезни следующему поколению. Образование и информирование населения о симптомах и методах лечения также являются важными аспектами борьбы с этим заболеванием.

Распространённость заболевания

Нередки случаи появления этой категории анемии в Африке, на Востоке, в Индии, Закавказье и других регионах с жарким климатом. Каждый год на планете появляется до трехсот тысяч детей с этой патологией.
Болезнь может протекать у пациента бессимптомно или, наоборот, наблюдается с тяжёлой клинической картиной и последствиями.
Но при этом такая болезнь способствует активированию защитного механизма от малярии.
Классификация
Талассемия — это генетическое заболевание, которое влияет на синтез гемоглобина, что может привести к анемии и другим серьезным проблемам со здоровьем. Люди, столкнувшиеся с этой болезнью, часто делятся своим опытом, подчеркивая важность ранней диагностики и регулярного медицинского наблюдения. Многие отмечают, что знание о своем состоянии помогает им лучше управлять симптомами и принимать меры для поддержания здоровья. Обсуждая талассемию, пациенты и их семьи акцентируют внимание на необходимости генетического консультирования, особенно для тех, кто планирует завести детей. Сообщества поддержки играют важную роль, предоставляя информацию и эмоциональную поддержку, что помогает людям не чувствовать себя одинокими в борьбе с этим заболеванием.

А — талассемия
Для болезни характерно подавление синтезирования альфа-цепей HbA. Может передаваться при помощи гетерозиготного носительства, с гомозиготной а-талассемией и другими патологиями. При этой болезни возникает дефект одного или нескольких генов. А-цепи не образуются, а процесс образования b-цепи глобина не меняется, из-за этого нарушается транспортировка газов у пациента.
Бета-Талассемия
При этом заболевании блокируется полностью или частично синтезирование бета-цепей. Вызывает это заболевание мутирование генов. Болезнь, как правило, распространяется в определённых зонах, но в ряде стран она развивается чаще других, например, в Италии, Греции, Сардинии, Таиланде.

Гамма-анемия и дельта-анемия
При этом заболевании нарушается синтезирование гамма-цепей и дельта-цепей.
Если такая проблема есть только у одного из родителей, то он может быть носителем заболевания, и оно протекает бессимптомно.
- При гомозиготной передаче болезни у пациента ярко выраженные симптомы, которые начинают беспокоить ребёнка уже с года. Её ещё называют большой талассемией.
- Малая талассемия передаётся по гетерозиготной форме и наследуется только от одного из родителей. Поэтому признаков малокровия практически нет, и симптомы почти отсутствуют.

- Тяжёлая. Её выявляют у детей 1 года жизни. Как правило, такие пациенты не живут более 12 месяцев после рождения из-за ярко выраженных симптомов болезни и изменений, которые происходят в развивающемся организме.
- Среднетяжелая. Клиническая картина этого заболевания выражена менее ярко, но, как правило, приводит к летальному исходу до достижения ребёнком возраста 8 лет.
- Лёгкая форма заболевания. Пациент при этой стадии болезни не доживает до подросткового возраста.
Причины
Врачи считают, что эта патология передается от родителей к ребёнку при помощи генов. Если заболеванию подвержен только один родитель, а от второго наследуется дефектная генетика, то такие люди являются носителями. У этих пациентов зачастую нет признаков болезни или проявляется только анемия.
Но если носитель талассемии планирует ребёнка, то он передаёт дефективную генетику своему потомству.
У людей, родители, которого оба болели талассемией, заболевание выражается в умеренной или тяжёлой форме.
В группу риска входят пациенты, в роду которых были больные этой патологии люди. Врачи отмечают, что наиболее распространена альфа-талассемия среди жителей Китая, Филиппин, других регионов Азии, а бета-талассемию чаще наблюдают у людей из Европы, Греции, Африки.
Стоит отметить, что присутствие этого заболевания в организме способствует выработке иммунитета против малярии.
Симптомы и признаки
Клиническая картина заболевания зависит от его разновидности и тяжести течения.
Общие симптомы, с которыми обращается пациент:
- Хроническая усталость.
- Слабость после физической активности или любого труда.
- Частое вздутие живота.
- Визуальная асимметрия костей черепа.
- Замедленное развитие роста и полового созревания пациента.
- Изменение цвета мочи с жёлтого на коричневый.
Кроме того, принято различать клинические проявления по типу заболевания.

- У пациента начинает бледнеть кожа.
- Происходит частое скопление газов в животе.
- Имеются яркие проявления анемии с младенческого возраста.
У больных бета-талассемией нередко проявляются:
- Изменения в костной ткани.
- Нарушается прикус зубов.
- На основе анализа выявляется анемия.
- Возможны резкие колебания сахара в крови.
- В младенческом возрасте возможны параличи, парезы, изменения в щитовидной железе.
Посмотрите видео про это заболевание
Диагностика
Анализ крови
Анализ крови при талассемии помогает диагностировать заболевание. У пациента понижается уровень гемоглобина до границы от 50 до 30 г/л. При этом уровень фетального гемоглобина увеличен и может достигать 90%.
При расчёте цветного показателя лаборант вычисляет коэффициент от 0, 5 и менее единиц.
Эритроциты во время этого заболевания меняют свою форму, потому что содержат гемоглобин, который способен изменять оболочку клеток, придавая форму овала, шара, серпа. Наиболее характерны для неё дрепаноциты, которые выявляются при просмотре мазка крови.
В крови количество ретикулоцитов увеличивается, как и уровень гемоглобина и железа в сыворотке крови. Если железо продолжает накапливаться, то это способствует развитию сахарного диабета, патологиям сердца, циррозу печени.
Электрофорез гемоглобина
Это самый достоверный метод лабораторной диагностики для выявления бета-талассемии. Для тяжёлой формы этого заболевания характерно увеличение показателя гемоглобина F от 20 до 90% от количества всего гемоглобина в организме для детей старше 12 месяцев. Обычно этот показатель составляет от 30 до 60%.
Если у пациента выявляется гомозиготная бета-талассемия, разновидность дельта-бета, то весь гемоглобин состоит только из вида F.
Исследование костного мозга
При исследовании пункции у пациента врач изучает клеточный состав костного мозга, проводя забор биологического материала при помощи стерильных инструментов. При помощи такого лабораторного исследования можно выявить увеличение количества клеток предшественников-эритроцитов. Такие клетки имеют свои характерные признаки. Они обладают маленьким размером, имеют светлый оттенок, в их центре скапливается гемоглобин.
УЗИ внутренних органов
Для выявления этого заболевания также используют УЗИ, которое позволяет оценить размер внутренних органов и их форму. Врачи для диагностирования используют УЗИ печени, селезёнки, почек и мочевого пузыря. При наличии заболевания печень увеличивается, она плотная, с неровными краями, возможно разрастание рубцовой ткани.
Изменениям подвергается и селезёнка. При талассемии она увеличивается, неоднородная, плотная, наполненная кровью.
При исследовании почек и мочевого пузыря нередко врачи отмечают наличие камней.
Диагностика талассемии у плода

Чаще всего это делается с целью прерывания беременности. Для этого проводят пункцию брюшной стенки матери, для того, чтобы взять на генетический анализ клетки плода, а также дополнительно проводится УЗИ.
Но стоит отметить, что такие методы могут спровоцировать выкидыш, инфицировать будущего ребёнка и даже вызвать смерть плода.
Лечение
Переливание крови
Одним из главных методов лечения остаётся переливание эритроцитарной массы от донора. Это позволяет замещать потерянный объем эритроцитов, не давая понижаться гемоглобину в крови.
Такой метод позволяет ликвидировать тяжёлое осложнение. Переливание начинают с возраста полугода. В это время за 14 дней проводится около 8 переливаний, потом чистота гемотрансфузий уменьшается. Оптимальный срок между переливаниями: 3–4 недели.
Эритроциты донора не содержат в себе дефектных клеток и способны функционировать на протяжении всего срока жизни.
Препараты
Десферал
Формы выпуска: порошок для приготовления инъекций. Рекомендуется использовать при отравлении железом, алюминием или их переизбытке в организме пациента. Используется для лечения талассемии, порфирии. Не рекомендуется при индивидуальной непереносимости. Стоимость 10 ампул начинается от 5000 рублей.
Хелаты
Это группа препаратов, в которой соединяются органические и неорганические вещества для облегчения усвояемости организмом. Эти средства менее токсичны и легко переносят высокую кислотность желудочно-кишечного тракта. Они легче усваиваются организмом и приносят меньше вреда.
Наиболее известными является хром хелат, цинк хелат, хелат железа.
Эти комплексы устраняют недостаток микро- и макроэлементов в организме, ускоряют рост пациента, борются с бессонницей, улучшают гормональный фон, способствуют восстановлению организма.
Их следует применять при активных физических нагрузках, анемиях разной этиологии, замедлении роста у детей, при пониженной массе тела и других явлениях. Не следует применять во время беременности, лактации, при аллергических реакциях.
Глюкокортикоиды
Преднизолон
Это лекарство наиболее эффективно при категории анемий, которые вызваны появлением антител в организме или при проблемах с костным мозгом и кроветворением. Эффективна терапия этим средством при талассемии. Дозировка препарата в сутки варьируется от 60 до 120 мг в день. Длительность лечения зависит от эффективности воздействия на организм пациента. Если лечение эффективно, то дозировка снижается до 20 мг. Средний курс лечения длится от 3 до 4 недель. Если в первые 2 недели нет эффекта, то лечение прекращается.
Форма выпуска: раствор для инъекций, таблетки, мазь, капли для глаз. Применяется при аллергиях, патологиях соединительной ткани, склерозе, хорее, дерматитах, онкологии, воспалении легких, гепатите. Используют лекарство для лечения лейкозов, анемий, отека мозга, болезней глаз.
Противопоказан при грибковых и паразитических инфекциях, непереносимости компонентов, болезнях желудочно-кишечного тракта, при СПИДе и т. д.
Стоимость лекарства в зависимости от формы начинается от 190 рублей.
Гепатопротекторы
Это группа лекарственных средств, которая помогает восстанавливать структуру клеток печени, предохранять орган от патогенного воздействия (алкогольные напитки, химия, калорийные блюда). Они снимают воспаление, обладают желчегонным действием, улучшают процессы кроветворения и обменные процессы.
Гепатрин
Форма выпуска: капсулы. Используется в качестве профилактической меры болезней печени и для комплексного лечения органа и желчевыводящих путей. Противопоказан во время беременности и лактации. Не рекомендуется для лечения детей до 12 лет и при непереносимости компонентов препарата. Цена начинается от 400 рублей за упаковку
Фосфоглив
Форма выпуска: капсулы. Лекарственное средство принимают при гепатитах, токсических поражениях органа, при гепатозах, при циррозах, при интоксикациях различного рода, при болезнях кожи. Не рекомендуется при индивидуальной непереносимости компонентов средства, при беременности и лактации. Не следует применять детям до 12 лет. Стоимость лекарства начинается от 1550 рублей.
Аскорбиновая кислота
Форма выпуска: драже, раствор для инъекций, порошок, таблетки. Лекарство используется в комплексной терапии для лечения талассемии, анемии, диатезе, инфекционных болезнях, кровотечениях, болезнях ЖКТ, болезнях печени, псориазе, дерматозе. Не рекомендуется при индивидуальной непереносимости компонентов препарата, при тромбозах и тромбофлебитах. Стоимость лекарственного средства начинается от 40 рублей.
Фолиевая кислота
Форма выпуска: таблетки. Рекомендуется применение лекарственного средства при анемиях, при авитаминозе фолиевой кислоты, при туберкулёзе кишечника, при гастроэнтерите. Не используют при непереносимости компонентов лекарственного средства, при анемиях, связанных с недостатком витамина В12. Стоимость таблеток начинается от 30 рублей.
Витамины группы В
Комбилипен Табс
В своём составе содержит В1, В6, В12. Форма выпуска: таблетки, раствор для инъекций. Длительность терапии варьируется от 2 до 4 недель. Рекомендуется для лечения полинейропатии, неврита, невралгии. Не следует применять, если у пациента есть проблемы с сердцем, беременность. Противопоказан кормящим матерям, детям и при склонности к аллергическим реакциям. Стоимость витаминного комплекса варьируется от 170 до 200 рублей.
Диета
Для пациентов, которые больны талассемией, необходимо соблюдения, согласно лечебному столу № 5. Чтобы Fe в кровь меньше всасывалось, необходимо включать в рацион чай и какао, есть больше сои и орехов.
Основные правила диеты основаны на химическом щажении органа и нормализации питании пациента.
В рационе должно быть нормализовано количество белков и углеводов, но уменьшено количество жирных блюд. Для продуктов используют отваривание, запекание, тушение.
Если овощ или фрукт содержит большое количество клетчатки, то его протирают блендером или на мясорубке. Жёсткое мясо рубят, а овощи не рекомендуется обжаривать.
Не следует есть и холодные продукты и блюда. Из рациона убирают продукты, содержащие пурины и блюда, провоцирующие клетчатку. Пациенту также рекомендуется ограничивать употребление соли.
Питание должно быть дробным, а пить воду следует не при приёме пищи, а натощак.
Разрешённые продукты
- Чай, разбавленный водой сок.
- Овощные супы, приготовленные не на мясных и рыбных бульонах.
- Вязкие каши (манная, овсяная, гречневая).
- Нежирное мясо и рыба, приготовленные на пару.
- Морепродукты.
- Хлебцы, хлеб.
- Молочные продукты пониженной жирности.
Запрещённые продукты
- Цикорий, кофе, алкоголь, газировка.
- Окрошка, супы на мясном бульоне, суп со щавелём.
- Бобовые.
- Острая паста.
- Блины, пирожки, сдоба.
- Солёные и жирные молочные продукты.
- Щавель, сырая капуста, томатная паста.
- Лимон, сырые овощи и фрукты.
- Орехи.
- Сало, майонез, уксус.
- Сгущёнка, шоколад, семечки.
Пример меню на 3 дня
День 1
- Паровые котлеты из рыбы. Гречневая крупа. Несладкий чай.
- Чернослив и зелёное яблоко.
- Суп-лапша на овощном бульоне. Рулет из мяса с луковой начинкой. Компот из ежевики.
- Слайсы и чай с ромашкой.
- Капустные котлеты с компотом. Несладкое печенье.
День 2
- Творожная масса с добавлением 10% сметаны и ложкой мёда. Чай.
- Запечённые в духовом шкафу, яблоки.
- Овощной суп-рассольник с добавлением рисовой крупы. Филе отварной курицы в соусе из сливок. Компот с добавлением смородины.
- Травяной чай с добавлением шиповника.
- Филе отварной рыбы и запечённый картофель. Творожник и чай.
- Кефир с низкой жирностью.
День 3
- Персиковый сок, разбавленный водой и паровой омлет.
- Творог со сметаной и травяной чай.
- Филе индейки с молочным соусом и манная крупа, сваренная на воде.
- Мусс из лесных ягод и чай.
- Суп-пюре с добавлением кабачков и картофеля. Отварное филе рыбы. Чай.
- Кефир с низкой жирностью.
Удаление селезёнки
Если у пациента наблюдается тяжёлая форма заболевания, то нередко размер органа может увеличиваться в несколько раз. Это приводит к множеству осложнений.
С помощью иссечения органа (спленэктомии) можно избежать множества проявлений.
Этот метод лечения для пациентов рекомендуется при разрушении эритроцитов в селезёнке, при увеличении концентрации мочевой кислоты в организме, при желтухе.
Перед хирургическим вмешательством следует проверить кровь пациента на свёртываемость. При необходимости пациенту требуется коррекция показателей крови.
Хирургическое вмешательство делают под общим наркозом с помощью лапаротомии (разрез в полости живота). Разрез ушивается с помощью ниток, а сверху накладывается стерильная повязка.
Пересадка костного мозга
Только с помощью этой методики удаётся полностью ликвидировать заболевание. Костный мозг у пациента полностью разрушается и заменяется донорским биологическим материалом.
Если костный мозг донора полностью приживается, то у человека начинается нормальное синтезирование глобиновых цепей.

Больного талассемией колют в этот период сильнодействующими лекарствами (например, циклофосфаном) разрушая его собственный костный мозг. Иногда с этой целью применяется облучение радиацией.
После уничтожения родного костного мозга через катетер вводится биологический материал, который взят у донора. Эта процедура похожа на обычное переливание.
После проведения пересадки костного мозга больного наблюдают на протяжении месяца, одновременно проводя переливания крови и антибиотическую терапию.
Если костный мозг прижился, то в организме больного начинает расти гемоглобин и нормализуются остальные показатели крови. В среднем, это наступает через 1,5 —2 месяца после пересадки.
На протяжении года необходим постоянный контроль за здоровьем пациентов со стороны врачей.
Талассемия и беременность
У беременных постоянно берут кровь на анализ, и если уровень гемоглобина в ней падает, то пациентке необходимо пройти ряд диагностических мероприятий, чтобы подтвердить или опровергнуть наличие заболевания.
Если болезнь есть у обоих родителей, то скорей всего у ребёнка будет тяжёлая форма болезни.
Если беременная не в курсе заболевания, то наверняка она просто является носителем талассемии. Но спровоцировать развитие болезни может изменение гормонального фона, уменьшение защитных сил организма.
Если у пациентки альфа-талассемия, то пациентка не чувствует ухудшения здоровья.
При бета-талассемии могут развиваться болезни печени, например, цирроз.
Кроме того, у женщины повышается риск развития водянки, выкидыша, преждевременных родов, может развиться диабет.
Вылечить это генетическое заболевание невозможно, беременной можно только поддержать своё состояние:
- Беречься во время эпидемий.
- Соблюдать специальное питание.
- Отказаться от вредных привычек.
- Следовать рекомендациям врачей.
Врачи рекомендуют проводить скрининговое обследование, чтобы понять, жизнеспособен ли ребёнок или лучше прервать беременность.
Кроме того, проводится симптоматическая терапия, направленная на удаление из организма излишков Fe, приём гепапротекторов, переливание эритроцитарной массы, специальная диета и другие методики.
Профилактика

Для обследования плода применяется фетоскопия и амниоцентез. Для исследований делают пункции через брюшную стенку и выполняют прокол. Биологический материал берут на генетическое исследование. Но эти методики имеют ряд побочных эффектов, например, вызывают преждевременные роды или могут инфицировать плод.
Если у родителей есть в роду люди, которые болеют талассемией, то до того, как планируется зачатие им необходимо пройти генетическое исследование.
Были проведены наблюдения в условиях, когда пациенты переселялись в другой климат.
Если человек переезжает с моря в горы, то его организм реагирует на смену жительства сначала увеличением давления и тахикардией, клетки крови начинают разрушаться и в ней остаётся необходимое количество эритроцитов и улучшается работа системы кроветворения, костного мозга.
Вывод
Талассемия – это заболевание, при котором нарушается синтезирование гемоглобина.
Форма патологий в зависимости от типа наследования и мутации может протекать, как с ярко выраженными симптомами, так и выражаться, как обычная анемия. Эта генетическая патология зачастую приводит к тяжёлым последствиям для всех систем организма и летальному исходу.
В зависимости от формы заболевания, пациент может прожить от 8 до 30 лет.
Универсального способа лечения от талассемии нет, и врачи, зачастую, ограничиваются симптоматическим лечением с помощью медикаментов, переливания эритроцитарной массы, иссечения селезёнки и других методик. Помогает поддерживать нормальное состояние здоровья и диета, основанная на столе № 5. Наиболее эффективным способом лечения признана донорская пересадка костного мозга. В случае успешной трансплантации показатели крови нормализуются.
Профилактических мер от талассемии практически нет, так как болезнь имеет генетическую природу. Но важно, чтобы родители, у которых есть болезнь, перед зачатием проходили генетическое исследование на жизнеспособность будущего ребёнка.
Вопрос-ответ
Что такое талассемия простыми словами?
Талассемия – это группа заболеваний, характеризующихся нарушением продукции гемоглобина. Они имеют наследственную природу и сопровождаются изменением структуры эритроцитов, что ведет к тотальной гипоксии тканей.
Что такое талассемия?
Талассемии — наследственные заболевания крови, для которых характерно снижение выработки гемоглобина. Симптомы зависят от типа патологии и могут варьироваться от незначительных до тяжёлых.
Можно ли вылечить талассемию?
Болезнь талассемия не излечивается до конца, поэтому суть лечения заключается в нормализации уровня гемоглобина в крови. При тяжелых формах заболевания больному необходимо постоянное переливание очищенных эритроцитов. Также нужно выводить из организма избыток железа с помощью препаратов группы хелатов.
Как узнать, есть ли талассемия?
Для установления диагноза талассемии выполняются анализы крови. Врачи измеряют уровни клеток крови и исследуют образец крови под микроскопом. Можно выявить характерные аномалии эритроцитов. Также выполняется еще один анализ крови, который называют электрофорезом гемоглобина.
Советы
СОВЕТ №1
Изучите основные типы талассемии. Понимание различий между альфа- и бета-талассемией поможет вам лучше осознать, как эти заболевания влияют на организм и какие симптомы могут возникать.
СОВЕТ №2
Регулярно проходите медицинские обследования. Если у вас есть семейная история талассемии или вы находитесь в группе риска, важно регулярно проверять уровень гемоглобина и другие показатели крови.
СОВЕТ №3
Обсудите с врачом возможные варианты лечения. Существуют различные методы управления талассемией, включая трансфузии крови и препараты для повышения уровня железа. Важно найти подходящий план лечения для вашего случая.
СОВЕТ №4
Поддерживайте здоровый образ жизни. Правильное питание, регулярные физические нагрузки и отказ от вредных привычек могут помочь улучшить общее состояние здоровья и снизить риск осложнений, связанных с талассемией.












